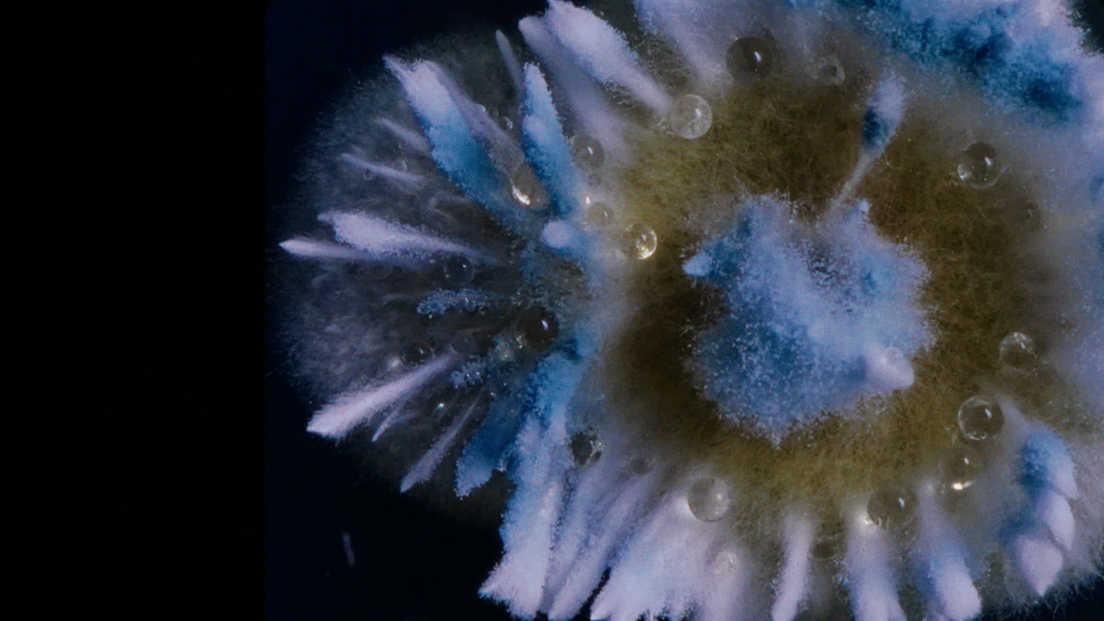
Dulkės, kaulai ir stebuklai

Dulkės, kaulai ir stebuklai
Dokumentinis Amžiaus cenzas: N-13 85 min.
„Dulkės, kaulai ir stebuklai“ – tai Aistės Žegulytės meninės dokumentikos filmas apie tai, kas amžina, o kas – laikina. Kol žmonės kovoja su laiku, mėgindami išsaugoti paveikslus, mirusiųjų kūnus ir savo prisiminimus, į jų erdvę veržiasi mikroskopiniai grybai.
A. Žegulytė („Animus Animalis“) sugrįžta su šešerius metus kurtu vizionierišku dokumentiniu filmu, kuriame greta įspūdingo mikrogrybų kultūrų gyvenimo atsiveria ir žmogaus santykis su istorija bei nenuilstamos pastangos nuo neišvengiamo nykimo apsaugoti tai, kas brangu. Filmo kūrėjai žiūrovus vedžioja meistrystės ir švelnaus humoro kupinais restauratorių kasdienybės koridoriais, pamaldumo ir pagarbos pripildytomis Valjadolido gatvėmis, pelėsio paveiktais, bet įtaigos nepraradusiais kinematografinės atminties vingiais. Žmonijos kūriniai neišvengiamai nyksta, tačiau žvelgiant pro mikroskopą blyksteli viltis. Nesustabdomas augimas tampa tylia, didinga pergale prieš mirtį.
„Dulkės, kaulai ir stebuklai“ šių metų kino festivalyje „Kino pavasaris“ išrinkta geriausia lietuviška premjera ir įvertinta Specialiu paminėjimu tarptautiniame konkurse. Prestižinio Amsterdamo dokumentinio kino festivalio (IDFA) konkursinėje programoje „Envision“ filmas apdovanotas už geriausią režisūrą, o Talino „Juodųjų naktų“ kino festivalyje laimėjo geriausio dokumentinio filmo apdovanojimą.
Atsiprašome, šiai dienai seansų nėra
Atsiprašome, šiai dienai seansų nėra










